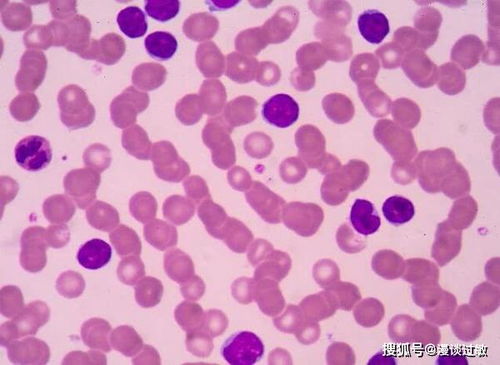
һ�θ�Σ�͸�Ⱦ���ܲ�

一次高危就感染了淋病
淋病 2026-01-29 12:49淋病治疗www.xingbingw.cn
一次高危性行为确实存在感染淋病的风险。我们不必因此而陷入恐慌。只要及时采取科学有效的应对措施,完全可以控制病情的发展。淋病是由淋球菌引起的,其潜伏期通常在2至10天之间,平均约为3至5天。如果出现尿道流脓、排尿灼痛等症状,应立即寻求医疗帮助。
面对这一健康威胁,你需要采取以下行动:
立即接受检查。前往医院接受尿道或宫颈分泌物检测、尿常规检查等,淋球菌涂片和培养是诊断的金标准。男性的症状可能较为明显,如脓性分泌物等,而女性可能症状较为轻微,但易引发盆腔炎等并发症,因此同样需要及时检查。
治疗过程其实相对简单。头孢曲松等抗生素通常可以在1到2周内治愈淋病。但必须按照医生的建议完成全程治疗,避免病情转为慢性感染。治疗期间,应禁止性行为,并且伴侣也需要同步进行检查和治疗。
在完成治疗之后,也不能掉以轻心,需要做好后续防护工作。安全套能够降低90%以上的传播风险。如果你经常面临高危性行为的情况,建议每3到6个月进行一次性病筛查,以便及时发现并处理潜在的健康问题。
面对这一健康挑战,你不必过于自责。据统计,约有20%至30%的男性通过单次无保护性行为感染淋病,女性的感染概率更高,达到30%至50%。现代医学手段已经非常成熟,只要及时处理,就不会有太大的问题。我们要更加珍惜自己的健康,做好防护措施,确保自己的性健康。健康才是我们最重要的资本,让我们共同呵护它吧!
上一篇:什么栓剂可以治疗淋病
下一篇:没有了
